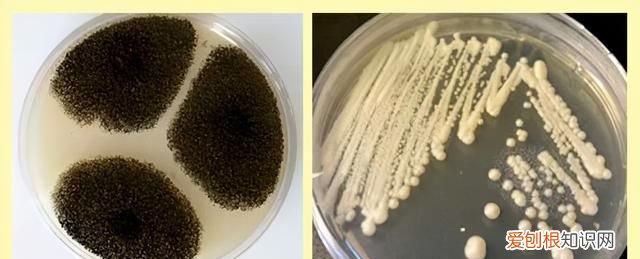
水果表面是好的里面是坏的是怎么回事

文章插图
这串葡萄的霉菌是长在果柄上,好像长不出太深的根是吧?可它上面能“结籽儿”啊,霉菌长出球状的孢子,随气流飘散 。在包装袋这种密闭空间内,葡萄身上早落满看不见的孢子了,说不定在你看不见的小伤口上已经开始繁殖了 。

文章插图
大部分霉菌不致命,但是很多霉菌的代谢产物是毒素 。像深绿色毛茸茸带着小黑点的霉菌,可能导致结核传染病 。而黄曲霉毒素等剧毒物质,被叫做“肝癌的幕后推手” 。
顺便说一句,疏松多孔的馒头啊面包啊,如果看见表面有霉点,也不能吃了 。
看到一个霉点,整个馒头都不要吃了 。看见一片面包上有霉点,整袋面包都不要吃了 。
和水果一样道理,宁可坏在外面也比坏在肚子里强 。

文章插图
03闻着有酒味儿的水果能不能吃?
像葡萄、红枣、猕猴桃、苹果、桃子、梨,多放几天就会闻出淡淡的酒味儿,分明是不新鲜了,但是算是坏了吗?
前面提到霉菌会落在水果伤口上,其实还有两类大军没说,一个是酵母菌,一个是细菌 。一般是酵母菌多,其次是霉菌,细菌最少 。
酵母菌咱都熟悉,吃掉水果里的糖,“拉”出酒精,让水果产生酒味儿,俗称发酵 。
能产生明显的酒味儿,说明酵母菌暂时抢占地盘成功,霉菌、细菌被压制住了,这时候只要水果不变酸,不变色,没有其他异味(如霉味、苦味),则可以继续食用 。
如果酒味儿里带着酸味,说明霉菌、细菌反扑成功,此时水果就不要吃了 。
文章插图
霉菌(左)和酵母菌(右),像极了恶魔与天使
04还真有食物发霉后切掉还能吃的
如果发现胡萝卜、甜椒、卷心菜、奶酪、硬香肠发霉,可以从距离发霉至少2.5cm远的地方切掉,剩余部分继续吃 。注意,刀子不要碰到发霉的部位 。

文章插图
还是那个道理,菌丝很容易往软的果肉里扎根,就很难往很硬的食物里扎根 。

文章插图
05如何处理发霉的食物?
如果已经看出来发霉,就不要再闻有没有坏味儿了,霉点上结满了孢子颗粒,万一被你吸进鼻腔里、肺里扎根就惨了 。就算是不得肺炎,诱发你过敏也是极坏的 。
发霉的食物,扔进有盖的垃圾桶里,或者扔到垃圾袋后扎紧口,防止孢子乱飘 。
扔完再检查检查它附近接触过的食物,是不是已经被传染 。能在水果上长的霉菌,基本也能在蔬菜上、面包馒头上长 。
如果是存放在冰箱里发霉的,可以把1小匙小苏打溶于一升水中,再拿洗碗布蘸小苏打水清洁冰箱 。
具体某种食物发霉如何处理,美国农业部曾经做过一个表格[2],我翻译过来,仅供参考:

文章插图
补一个小tip,土豆、柚子和橙子、柠檬、西葫芦、红薯、洋葱、大蒜,为避免冻伤就不用放冰箱了 。
李子、芒果、桃子和梨、香蕉,可以先室温存放,熟了还吃不完再放冰箱 。
今天看了这么多各种烂脸的水果,还有没有心情吃晚饭啊?我反而馋了怎么回事,写完文章去买了一堆水灵灵的水果,还是新鲜的味儿正啊 。把我转发到相亲相爱一家人群里,我替你劝劝舍不得扔烂水果的家人!
推荐阅读
- cpu占用率过高怎么办
- 冲牙器是刷牙后使用吗
- 割礼指的是什么 割礼是什么意思
- 数学什么叫质数什么叫合数
- Up直播如何关闭礼物特效
- 平足是什么
- 评为烈士有什么待遇
- 玄凤吃什么菜和水果
- 朋友圈深夜说说心情短语 说说心情 深夜朋友圈
